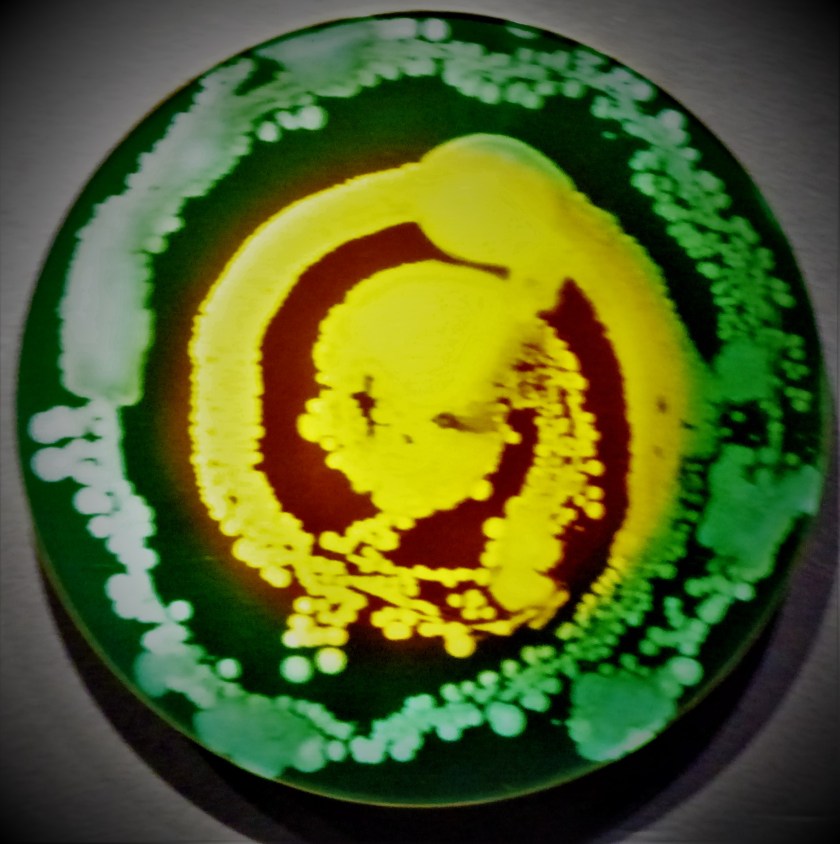
P1290395 (2)

INTRODUCTION
This is my third and last post about our family outing to the Eden Project, covering the Mediterranean Biome.
MEDITERRANEAN IN CONTEXT
There are other parts of the world that have the same type of climate as the Mediterranean – parts of South Africa, southwestern Australia and parts of the USA, and they all feature in this Biome. There was much bird life in evidence in the Biome as well. My camera got steamed up and I failed to notice, so the photographs did not come out as well as I would have liked, but nonetheless I share them. After we had finished in this Biome we had a late lunch (sausage casserole with accompanying vegetables in my case, washed down with a bottle of locally brewed beer – from St Austell, the closest town of any significance) and then made our way back to the car park, availing ourselves of the bus from the visitor’s centre because I was getting tired by then (a legacy of the cancer that nearly killed me at the back end of 2018). I will certainly be visiting this place again in the not too distant future and would list at as an absolute must see place if you are visiting Cornwall.